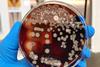
shutterstock_2371136393

All Anaelle Tannen articles
-
 News
NewsSepsis: addressing unmet needs for a global priority
Limited funding and a lack of drugs targeting the root cause of sepsis are some of the current obstacles when addressing the disease burden, GlobalData says.
-
News
NewsCould novel antibiotic successfully treat a ‘priority 1 pathogen’?
Highlighting the potential of a novel antibiotic against acinetobacter infections, GlobalData explained that nine other drugs, alongside this promising treatment, are in clinical development for this indication.



